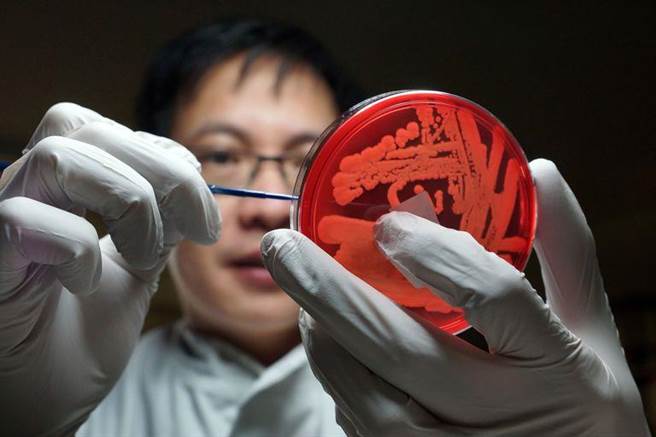
金黄色葡萄球菌是一种在环境中极之普遍存在的细菌，全世界人口有约三分之一的体内带有（verywell）

生物学家鼻内发现新抗生素 有望抵抗超级细菌

科学家在鼻子内发现可以抵抗超级细菌的抗生素
寻找新药物来对抗日益流行的耐药细菌的生物学家们,在一个意想不到的地方找到一种抗生素-人类的鼻子内,生物学家报称,这种化合物由鼻栖细菌产生,能杀死被称为“超级病菌”的耐甲氧西林金黄色葡萄球菌(MRSA,Methicillin-resistant Staphylococcus aureus)。
研究报告的共同作者德国蒂宾根大学的佩舍尔(Andreas Peschel)说,发现与人有关的细菌产生一种真正的抗生素,完全出乎意料之外。他说表示已展开更大的筛查计划,肯定会由这些来源发现更多额外抗生素。一般抗生素化合物通常由生活在土壤中的细菌处获得,在人体内发现实属罕见。

携带路邓葡萄球菌的病人中,感染金黄色葡萄球菌的比例为 5.9%,而在未携带路邓葡萄球菌的病人中,该比例高达 34.7%(netdoctor)
佩舍尔和他的团队在研究为何 30% 的人鼻子内有金黄色葡萄球菌,而 70% 人则没有时意外发现这个研究成果。金黄色葡萄球菌是其中一种最常见的严重细菌感染原因,夺去很多人的性命。一种金黄色葡萄球菌菌株已发展出抗生素耐药性。研究人员把一种在鼻子内较常见的路邓葡萄球菌,分离出能够对抗金黄色葡萄球菌的抗生素,他们称它为路邓素(Lugdunin)。
研究人员检查了 187 名住院病人的鼻腔分泌物,发现在携带路邓葡萄球菌的病人中,感染金黄色葡萄球菌的比例为 5.9%,而在未携带路邓葡萄球菌的病人中,该比例高达 34.7%。这表明,在人体鼻腔中,路邓葡萄球菌似乎有助于抑制金黄色葡萄球菌。研究人员称,由于处于研发中的新型抗生素不多,该研究具有一定的临床意义,而且凸显了人体微生物作为新型抗生素潜在来源的价值。
金黄色葡萄球菌是一种在环境中极之普遍存在的细菌,全世界人口有约三分之一的体内带有它,而在一般的健康情况下并不会造成任何问题。过去,葡萄球菌只会在弄伤皮肤或伤口处造成感染。但最近却由于过度使用抗生素的缘故,金黄色葡萄球菌的菌株已形成抗药性。若免疫系统出现弱点时,纵然没有伤口亦可以导致抗药性金黄色葡萄球菌感染。症状会是疖,甚至于坏死性筋膜炎。
金黄色葡萄球菌是一种在环境中极之普遍存在的细菌,全世界人口有约三分之一的体内带有(verywell)
金黄色葡萄球菌一般都是植菌在鼻前孔,可能会令呼吸道、伤口、静脉导管及尿道的皮肤及软组织感染,引致脓疮、红肿、发热及流脓。 MRSA 感染通常都是没有症状的,而且可以维持长达数个星期至几年的时间。感染病人的若免疫系统受损,相比起有症状的继发感染病人,会有着更大的危险。

发表你的评论吧返回顶部
!评论内容需包含中文
